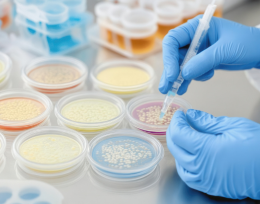

Vitrine tecnológica
- Meio Ambiente
- Saúde e Bem-estar
- Engenharias
- Inovação
- Agronegócio
- Comércio Exterior
- Nanotecnologia
-

Arqueologia e Gestão Integrada do Território
-

Atenção à Saúde e Epidemiologia
-

Biotecnologia Peptídica Aplicada ao Desenvolvimento de Novos Fármacos – Biotech
-

Grupo de Pesquisa em Doenças Cerebrovasculares
-

Grupo de Pesquisa em Epidemiologia
-

Grupo de Pesquisa em Exercícios Aquáticos Avançados
-

Grupo de pesquisa em Fabricação Mecânica
-

Grupo de Pesquisa em Gastronomia e Turismo
-

CERTEC - Grupo de Pesquisa em Cerâmica Técnica
-

Grupo de Pesquisa em Genética Toxicológica
-

Grupo de Pesquisa em Gestão do Cuidado, Integralidade e Educação na Saúde (GECIES)
-

Grupo de Pesquisa em Inteligência Artificial Aplicada
-

Grupo de Pesquisas em Odontologia
-

Grupo de Reatores e Processos Industriais
-

Habitação, Espaço Público e Cidade
-

INOVA LIDE - Grupo de Pesquisa em Inovação, Liderança e Estratégia
-

Laboratório de Desenvolvimento de Biomateriais e Materiais
-

Laboratório de Metalurgia e Tratamento de Resíduos Industriais -
-
Laboratório de Microbiologia Experimental
-

CEPOL - Ciência e Engenharia de Polímeros
-

Laboratório de Processamento e Polímeros Avançados
-

Desenvolvimento em Realidade Aumentada e Dispositivos Móveis
-

Desenvolvimento Socioeconômico, agricultura familiar e educação do campo
-

Direito à Cidade e Políticas de Sustentabilidade Urbana e Ambiental
-

Núcleo de Estudos em Engenharia de Produção - NEEP
-

Proteção e Reparo Tecidual
-

VALORA - Valorização de Resíduos como Estratégia para o Desenvolvimento da Economia Circular
-

Doenças Neurodegenerativas
-

Grupo de Estudos e Pesquisas em Produção, Agronegócio e Desenvolvimento - GEPPAD
-

Ecologia da polinização e interação animal-planta
-

Ecologia e Manejo de Ecossistemas Degradados
-

Fenômenos de Superfície e Tratamentos Térmicos
-

Fermentare
-

Gestão de recursos hídricos e restauração de ambientes alterados
-

GENINT - Gestão e estratégia em negócios internacionais
-

GPDECC - Grupo de Pesquisa em Desempenho de Estruturas e Construção Civil
-

Grupo de Biomateriais e Materiais Nanoestruturados
-

GEPPLAM - Grupo de Extensão e Pesquisa em Plantas Medicinais
-

Grupo de Materiais Cerâmicos
- Nenhum resultado encontrado


